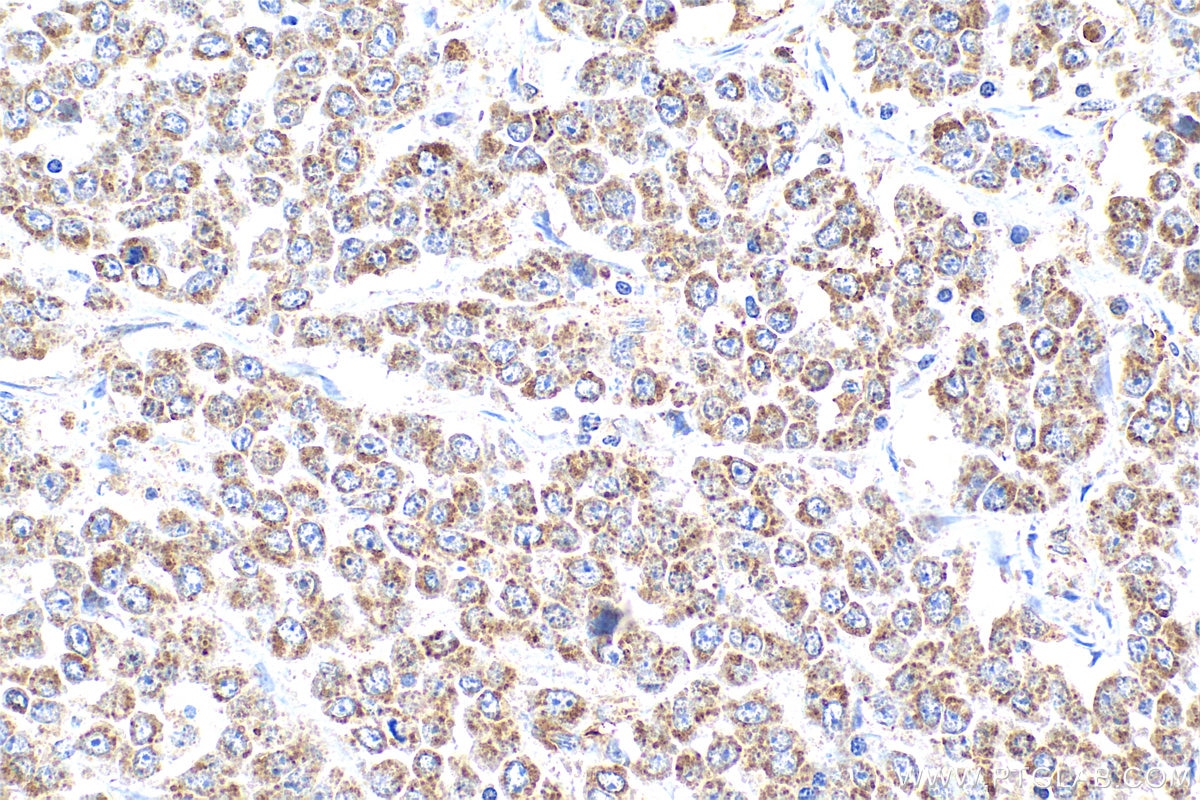

Tested Applications
| Positive IHC detected in | human colon cancer tissue Note: suggested antigen retrieval with TE buffer pH 9.0; (*) Alternatively, antigen retrieval may be performed with citrate buffer pH 6.0 |
Recommended dilution
| Application | Dilution |
|---|---|
| Immunohistochemistry (IHC) | IHC : 1:200-1:800 |
| It is recommended that this reagent should be titrated in each testing system to obtain optimal results. | |
| Sample-dependent, Check data in validation data gallery. | |
Published Applications
| WB | See 5 publications below |
| IHC | See 3 publications below |
| ELISA | See 1 publications below |
Product Information
14738-1-AP targets DEFB1 in WB, IHC, ELISA applications and shows reactivity with human samples.
| Tested Reactivity | human |
| Cited Reactivity | human, mouse |
| Host / Isotype | Rabbit / IgG |
| Class | Polyclonal |
| Type | Antibody |
| Immunogen |
CatNo: Ag6406 Product name: Recombinant human DEFB1 protein Source: e coli.-derived, PGEX-4T Tag: GST Domain: 1-68 aa of BC047677 Sequence: MRTSYLLLFTLCLLLSEMASGGNFLTGLGHRSDHYNCVSSGGQCLYSACPIFTKIQGTCYRGKAKCCK Predict reactive species |
| Full Name | defensin, beta 1 |
| Calculated Molecular Weight | 7 kDa |
| GenBank Accession Number | BC047677 |
| Gene Symbol | DEFB1 |
| Gene ID (NCBI) | 1672 |
| RRID | AB_2091826 |
| Conjugate | Unconjugated |
| Form | Liquid |
| Purification Method | Antigen affinity purification |
| UNIPROT ID | P60022 |
| Storage Buffer | PBS with 0.02% sodium azide and 50% glycerol, pH 7.3. |
| Storage Conditions | Store at -20°C. Stable for one year after shipment. Aliquoting is unnecessary for -20oC storage. 20ul sizes contain 0.1% BSA. |
Protocols
| Product Specific Protocols | |
|---|---|
| IHC protocol for DEFB1 antibody 14738-1-AP | Download protocol |
| Standard Protocols | |
|---|---|
| Click here to view our Standard Protocols |
Publications
| Species | Application | Title |
|---|---|---|
Sci Rep β-defensin 1 expression in HCV infected liver/liver cancer: an important role in protecting HCV progression and liver cancer development. | ||
Indian J Gastroenterol Antibacterial spectrum of human omentum and differential expression of beta defensins. | ||
Cureus Expression of Antimicrobial Peptides and Cytokines in Human Omentum Following Abdominal Surgery | ||
Biomed Pharmacother Shen Qi Wan ameliorates nephritis in chronic kidney disease via AQP1 and DEFB1 regulation | ||
Int Immunopharmacol Edaravone alleviates Pseudomonas aeruginosa associated-acute lung injury by inhibiting inflammation and promoting anti-microbial peptide production | ||
Clin Proteomics Multi-omics analyses, cell experiments, and network pharmacology tools identified key proteins and candidate drugs for alopecia areata treatment |